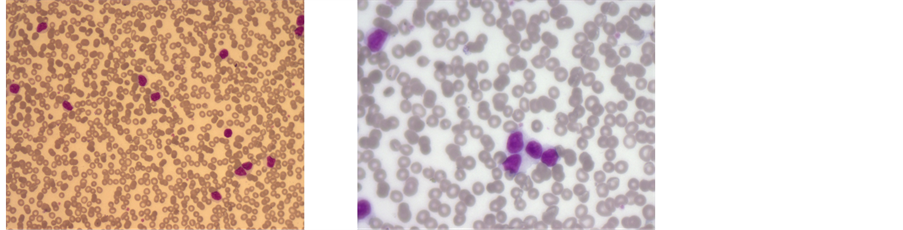

Journal of Cancer Therapy
Vol.07 No.06(2016), Article ID:67641,12 pages
10.4236/jct.2016.76045
Comprehensive Genetic Analysis by Integration of Conventional Karyotyping and Interphase FISH Helps Refinement of Biological Subclasses with Clinical Impact in Chronic Lymphocytic Leukemia
P. S. Kadam Amare1*, S. Kakade1, K. Chopra1, M. Sengar2, H. Menon2, H. Jain2, B. Bagal2, P. G. Subramanian3, S. Gujral3
1Cancer Cytogenetics Department, Tata Memorial Hospital, Mumbai, India
2Department of Medical Oncology, Tata Memorial Hospital, Mumbai, India
3Hematopathology Laboratory, Department of Pathology, Tata Memorial Hospital, Mumbai, India

Copyright © 2016 by authors and Scientific Research Publishing Inc.
This work is licensed under the Creative Commons Attribution International License (CC BY).
http://creativecommons.org/licenses/by/4.0/



Received 25 May 2016; accepted 20 June 2016; published 23 June 2016
ABSTRACT
Background: Various genetic technologies have been employed in the identification of genomic complexity and refinement of prognostic classification of clinically heterogeneous disease of chronic lymphocytic leukemia (CLL). Objective: The present study of interphase cytogenetics and conventional karyotyping was undertaken to perform comprehensive analysis of CLL genetics with an approach to refine early prognostication of disease. Material & Methods: Retrospective analysis by fluorescence in situ hybridization (FISH) was carried out on total 671 patients of CLL at diagnosis between 2008 and 2015. Conventional cytogenetics studies were performed in 50 of 671 patients using CPG Oligonucleotide + IL-2 and TPA (12-O-Tetradecanyl Phorbol 13-acetate) for stimulation of lymphocytes cultures. Results: Interphase cytogenetics could detect recurrent abnormalities such as del(13q14), +12, del(17p13), del(11q22), del(6q23) in 71% of cases. The incidence of del(13q) was higher in Rai stage 0, I, II (p = 0.0005); whereas patients with ≥2 aberrations were more common in advance stage III, IV (p = 0.001). Frequency of IgH translocation was 7%. Morphology and immunophenotypic analysis revealed atypical CLL with higher frequency of t(14;19) than t(14;18). Conventional karyotype could detect abnormal karyotype in 97% of cases which displayed targeted FISH abnormalities along with additional non-targeted chromosomal abnormalities. Patients with negative FISH markers showed clonal non-recurrent numerical and structural changes. The complex karyotype was identified in 24% cases which included targeted FISH aberrations as well as non-targeted numerical and structural abnormalities like deletions, and unbalanced translocations. A significant association was observed between complex karyotype and coexistence of ≥2 FISH markers (p = 0.009) and del(11q22) &/or del(17p) (p = 0.03). Conclusion: Our data of interphase FISH with integration of conventional karyotyping revealed genomic complexity that helped identification of biological subclasses with clinical impact at diagnosis. Further, these cytogenetic subclasses along with molecular markers are likely to evolve more refined prognostic groups, which will help design risk-adapted therapies in B-CLL.
Keywords:
CLL, FISH, Complex Karyotype, Biological Subclasses, Prognostic Groups

1. Introduction
Chronic lymphocytic leukemia (CLL) is a clinically heterogeneous disease with variable response to chemotherapy, survival period from less than one year to more than 15 years [1] - [4] . Rai and Binet staging has limitations with respect to early prediction of chemotherapy response, progression or future course of disease [3] - [6] . Over a period of two decades, various genetic technologies like Fluorescence In-situ Hybridization (FISH), conventional karyotyping, genomic microarrays, gene sequencing have played a significant role in the refinement of genomic complexity [7] - [19] . Donher et al. [20] who established interphase cytogenetics in B-CLL, is still a gold standard, simple laboratory technique, able to detect recurrent chromosomal abnormalities, del(13q), trisomy 12, del(11q), del(17p), del(6q) with distinct prognosis in 70% - 80% of CLL patients [9] - [12] [17] [21] .
Although gold standard, targeted nature of interphase cytogenetics limits its contribution in the assessment of comprehensive genomic assessment, the detection of additional clonal abnormalities apart from recurrent aberrations by conventional karyotyping helps identification of different genetic subclasses with distinct prognostic classification [8] [9] [14] [22] - [24] .
Recently, complex karyotype with IgVH mutation has been found to be a high risk group in CLL [7] - [9] [14] [25] [26] . Attention was also focused to 14q32 translocation involving IgH gene [27] - [29] . Cavazzini et al. (2011) [29] found clonal evolution in complex karyotypes in cases with IgH translocation and these cases were associated with chemorefractory to standard/targeted regimens.
The present study was undertaken 1) to evaluate the frequency of recurrent interphase FISH abnormalities which include del(13q14), +12, del(11q22), del(17p13), del(6q23) and correlate these markers with clinico-pa- thological parameters, 2) to evaluate frequency and characterization of IgH translocations and their association with typical & atypical CLL, 3) to investigate comprehensive analysis of genetic picture by conventional karyotyping, & 4) to correlate complexity and/or non-complexity of karyotypic picture with FISH results & clinical variables.
2. Material & Methods
A total of 671 CLL patients (512 Males & 159 Females, Age Range: 24 - 92 years, Median Age: 58 years, M:F Ratio: 3.2) diagnosed by standard morphology and immunophenotypic criteria between May, 2008 and Dec, 2015 at the Department of Medical Oncology, Tata Memorial Hospital, were included in the present study. The diagnosis of atypical CLL included morphology (nuclear indentation) and immunophenotype (CD 22+ve, CD 23 dim/−ve, surface Ig weak and FAM7 +ve). FISH and conventional karyotyping studies were performed at diagnosis before the decision of treatment initiation. Those patients who needed treatment were treated with standard chemotherapy including Fludarabin, Chlorambucil and Cyclophosphamide.
FISH was performed on interphase cells from bone marrow aspirate and/or peripheral blood with panel of probes that includes LSI D13S319(13q14.3)/LSI 13q34, CEP 12, LSI(17p13.1)/D17Z1, LSI ATM(11q22)/ D11Z1, LSI MYB(6q23)/D6Z1, LSI IgH break apart, LSI dual fusion IgH/CCND1, IgH/BCL2, IgH/BCL3 and C-MYC break apart probe (Abbott Molecular, Delkenheim, Germany and Kreatech Diagnostics, The Netherland). FISH protocol followed as described previously [17] [20] . Minimum 200 cells were scored in each specimen. The cut off threshold for trisomy and dual fusion probes was 2%. The cut off threshold for LSI 13q14 deletion, ATM deletion, and 6q deletion was 5%. The baseline value for TP53 deletion and break apart probe for IgH & C-MYC was 7%. Patients with ≥2 FISH markers were grouped under coexistence of ≥2 aberrations. IgH translocation studies were carried out in a cohort of 557 out of 671 patients (Age Range: 37 - 88 Years).
Conventional karyotyping was performed in 50 patients from a cohort of 671 patients. The target materials were bone marrow aspirate and/or peripheral blood which were cultured in HAM F10 with 10% fetal calf serum along with immunostimulatory CPG oligonucleotide DSP 30 (2 µM) (TIB MOL BIOL, Berlin, Germany) in combination with Interleukin-2 (IL-2) (200 units/ml) (Roche, Sydney, Australia). Simultaneously, cultures were also stimulated with TPA (12-O-tetradecanoyl phorbol 13-acetate) (50 ng/ml) [7] . After 72 hrs of stimulation, cultures were terminated and chromosome preparation was done as per standard protocol. The correlation of FISH markers with clinical variables and with conventional karyotyping findings was evaluated by Pearson’s chi-square test (SPSS version 20).
3. Results
3.1. FISH Findings at Diagnosis
Table 1 summarizes frequency of FISH markers including del(13q14)/-13, +12, del(11q22), del(17p13), del(6q23) in a cohort of 671 patients (Figure 1). The frequency of FISH recurrent markers was 71% (477/671).
Figure 1. (a) Interphase FISH with LSI 13S319(13q13.4) and LSI 13q34 (control) shows heterozygous, monoallelic 13q14 deletion (1R2G); (b) Biallelic, homozygous 13q14 deletion (0R2G); (c) Monosomy 13(1R1G); (d) CEP 12 probe shows trisomy 12(3R); (e) LSI ATM(11q22) and D11Z1 (control) shows heterozygous 11q22 deletion (1R2G); (f) LSI TP53 (17p13.1) and D17Z1 (control) probes show heterozygous TP53 deletion (1R2G); (g) LSI MYB(6q23) and D6Z1 (control) probes show heterozygous 6q23 deletion (1R2G).
A 13q biallelic deletion was detected in 30/288 (10%) cases (Figure 1(b)). There was no association of monoallelic/biallelic deletion with stage of the disease (Mono 90% & Bi 10% in 0, I, II vs 87% & 13% in III, IV (p = 0.52). The co-existence of ≥2 aberrations was detected in 139/477(29%) of FISH positive group. The clone size of aberrant FISH markers was 5% - 95%. Among the FISH positive group, Abn(13q) occurred as a most frequent sole abnormality: 38% (181/477) followed by trisomy 12: 17% (83/477), del(11q), del(17p): 6% (29- 30/477) each and del(6q): 8% (15/477). In a group of ≥2 aberrations, Abn(13q) was most common, 22% (107/477), followed by Abn(17p), 15% (71/477), del(11q), 12% (58/477), trisomy 12, 9% (45/477) and del(6q), 7% (36/477). In a cohort of 477 cases of positive FISH markers, Rai staging was available in 432 cases, of which 183 and 249 cases were in stage 0, I, II and III, IV respectively. Among all FISH positive markers, del(13q)/-13 was associated with lower age group (p = 0.02).The correlation of Rai staging system with FISH markers revealed association of Abn(13) with lower stage group (0, I, II) (p = 0.0005); on the other hand ≥2 aberration positive FISH group revealed association with advanced stage (III & IV) (p = 0.001) (Table 2).
The frequency of IgH translocations in a cohort of 557 cases was 7% (42/557). The translocations were characterized as t(14;18)(q32;q21)(41%:17/42), t(14;19)(q32;q13)(24%:10/42), t(8;14)(q32;q24)(2%:1/42) and variant IgH translocations (33%:14/42) (Figure 2). In 32 out of 42 cases, morphology details and immunophenotypic analysis revealed atypical CLL in 20 cases, in which frequency of t(14;19) was higher in comparison with t(14;18) (Table 3, Figure 3). The CD38 was more common in t(14;19)(5/7) and t(14;18)(7/13) positive cases.
Table 1. Frequency of FISH targeted markers by FISH in CLL in present study (n = 671) and incidence in reported literature.
Table 2. Correlation of FISH genetic groups with age and stage of the disease (n = 432).
Table 3. Frequency of t(14;18), t(14;19), t(8;14) and variant IgH translocations in Atypical and Typical CLL (n = 32).
Figure 2. (a) Interphase FISH with LSI IgH dual colour break apart probe shows IgH translocation (1R1G1Y); (b) Dual fusion IgH/BCL2 translocation probe shows standard IgH/BCL2 (1R2G2Y); (c) Dual fusion IgH/BCL3 translocation probe shows IgH/BCL3 (1R1G2Y); (d) LSI C-MYC dual colour break apart probe shows C-MYC translocation (1R1G1Y).
Figure 3. Bone marrow morphology shows heterogeneous mixture of small and medium sized lymphocytes with indented nuclei.
IgH translocations were most frequently accompanied by trisomy 12(53%:22/42) followed by del(13q) (28%: 12/42) (Table 4). Clone size of IgH translocation, trisomy 12 and del(13q) revealed that IgH translocation was a primary event.
3.2. Conventional Karyotyping (CK) Findings and Comparison of FISH and Conventional Karyotyping (Table 5)
Of total 50 specimens, successful cultures were obtained in 40(80%) specimens. Both CPG-oligonucleotide DSP 30 +IL-2 and TPA stimulation showed almost equal proliferative index. A minimum of 10 - 20 metaphase cells were karyotyped in each specimen. Of total 40, 31 preparations with 200 - 300 G-band resolution were karyotyped and of the total 30/31 specimens (97%) displayed abnormal karyotype (Figure 4, Figure 5).
Interestingly, 2/11 cases with no targeted abnormalities by FISH displayed clonal abnormalities del(13) (q14q22) (Figure 4(b)) and trisomy 12 by CK; whereas 7/11 cases with negative FISH markers showed deletions affecting chromosomal loci 8p11, 9p11, 11q22-23, 12p13, 14q11.2-q24, 15q11.2-15 (Figure 4(d)), 15q22.3-24, 18p11, balanced translocations t(1;14)(q42;q32), t(14;18)(q32;q21) and unbalanced 14q32 translocation. Overall 29% (9/31) cases with negative FISH markers revealed either targeted FISH markers and/or other non-recurrent chromosomal abnormalities. The remaining 21 out of 31 cases with targeted abnormalities by FISH panel of probes revealed the same abnormalities in clonal form in respective karyotypes (Table 5). Two cases with targeted FISH aberrations, del(17p) & del(11q) disclosed additional targeted /non-targeted abnormalities such as del(13q14q22) and del(6q22). Of 21 cases with targeted FISH abnormalities, 15 cases displayed additional numerical abnormalities, gains and losses of various chromosomes viz, +6, −8, +8, +11, −14, −18, +19, +20, +21, +22 and structural abnormalities such as del(1)(q21), del(1)(q11), del(1)(q25), i(1p), del(4p15), del(7q32), del(13)(q12q14), del(13)(q14q22), del(16q22), del(15q24), del(18p11), unbalanced translocations, t(14q32), t(7p22), t(11q21), t(12p13), t(14p11), t(10q24), t(15q25) (Figure 4(c)), and balanced translocations t(13;14)(q22;q32) (Figure 4(a)). Overall 71% (22/31) cases had heterogeneous chromosomal abnormalities.
Table 4. Association of FISH markers [+12, del(13q/-13), del(11q22)] with IgH translocations.
Figure 4. (a) Partial karyotype of a case with del(13q) by FISH shows del(6)(q23) and t(13;14)(q22;q32); (b) Partial karyotype of a case with del(13q) by FISH shows del(13)(q14q22), del(7)(q32); (c) Partial karyotype of a case with del(13q) by FISH shows t(?;15)(?;q25) as an additional abnormality; (d) Partial karyotype of a case with negative FISH shows del(15)(q11.2q15).
Table 5. Karyotyping and FISH markers details in the present study (n = 31).
Figure 5. Conventional karyotype of a case with del(6q23) and del(11q22) by FISH shows complex karyotype with del(6)(q23), +11, del(11q)(q22), +12, −14.
In a cohort of 31 cases, 7 cases (24%) had complex karyotype. All cases with complex karyotype had targeted FISH aberrations like del(13q), +12, del(11q), del(17p), del(6q) and also additionally displayed numerical as well as structural abnormalities like deletions, and unbalanced translocations (Table 5, Figure 5). A significant association was observed between complex karyotype and coexistence of ≥2 FISH markers (p = 0.009) and del(11q22) &/or del(17p) (p = 0.03). A significant association was found between non-complex karyotype and cases with negative FISH markers (p = 0.01) (Table 6).
4. Discussion
The incidence of targeted FISH abnormalities was 71% in our series of 671 patients of B-CLL and that was consistent with the range (60% - 80%) of reported studies [10] - [12] [17] [22] [30] [31] . As summarized in Table 1,
Table 6. Correlation of FISH markers with complex and non-complex karyotype (n = 31).
del(13q)/-13(43%) was most common, followed by trisomy 12(19%), del(17p)(15%), del(11q)(13%) and del(6q)(8%) [10] - [12] [21] [22] [31] . Although reported incidence of del(17p) is 4% - 15%, the frequency in our series of del(17p) was towards higher side 15% than del(11q22)(13%). The correlation of Rai staging with 17p deletion showed no significant association of del(17p) with stage of the disease in B-CLL which may indicate that del(17p) may not necessarily be associated with disease stage, rather it occurs frequently in progressive disease [11] [12] [18] [21] [32] . In the present study, the identification of progressive vs non-progressive disease and treatment response with cytogenetic findings was not possible due to unavailability of clinical follow up.
A biallelic 13q deletion with incidence of 9% - 10% has been observed in other studies. We did not find correlation between mono/biallelic 13q deletion with age and stage of disease. The clinical impact of an biallelic 13q deletion is controversial [11] [33] [34] .
The predominant clone of abn(13q) in cases with coexistence of ≥2 abnormalities is consistent with reported studies, which confirmed that abn(13q) is a most common genetic event [10] [12] [17] [21] [31] . The frequencies of all FISH markers as a sole aberration and in combination with other recurrent markers revealed that del(11q22) and del(17p) occur frequently in combination with other recurrent FISH marker/s rather than sole aberration. We found correlation of Abn(13q) with lower age and lower stage of disease. There was no association of high risk markers del(11q) and del(17p) with either variable age or stage of the disease, whereas group of coexistence of ≥2 abnormalities was associated with Rai stage III, IV. Study by Quijano et al. [11] found higher proliferative index in B-CLL patients with co-existence of del(13q) & del(17p). The review of literature emphasized that del(17p), a high risk progressive group commonly seen in association with high risk factors like unmutated IgVH, CD38 positivity rather than stage of disease [10] [11] [13] [14] [18] [22] [32] [35] .
The frequency of IgH translocation in our study was 7%, is consistent with reported studies 4% - 9% [9] [27] - [29] . Overall, 62% of IgH translocation +ve cases belonged to atypical CLL in which CD38 was present in 38% of cases. Translocation (14;18) and t(14;19) were most predominant (64%). The review of literature has also shown involvement of BCL2 and BCL3 as commonly affected partner genes [25] [27] - [29] . The association of IgH translocation with trisomy 12 followed by del(13q) as additional aberrations and the clone size of aberrant nuclei with IgH translocation, +12, del(13q) revealed that IgH translocation may be a primary event . Previously reported studies on IgH translocation in B-CLL have shown an association of IgH translocation with unmutated IgVH, ZAP70 expression, CD38 positivity, atypical nuclear morphology, atypical immunophenotype [7] [27] - [29] .
Conventional karyotyping with stimulated cultures with CPG Oligonucleotide with IL-2 as well as TPA found to be very efficient strategy as compared to FISH, enabled to detect targeted FISH aberrations as well as non-targeted comprehensive chromosomal aberrations in 97% of cases. Overall, 71% of cases had heterogeneous chromosomal abnormalities with affected loci other than FISH targeted loci which were present as either sole or as additional abnormalities along with FISH markers. We could efficiently identify large 13q deletion, del(13)(q12q14) & del(13)(q14q22) in two cases, where FISH failed to detect these non-targeted large deletions. Large deletions covering 13q12q14/q14q22 which fall in class II deletion cover RB1 and many additional genes, which may drive disease progression probably through involvement of novel genes pathways [36] [37] . The complex karyotype frequency of 24% falls in the range of 15% - 25% in the studies reported earlier [7] - [9] [14] [25] [26] . The numerical abnormalities and structural abnormalities affecting various chromosomal loci in complex and non-complex karyotypes were heterogeneous. Some of these abnormalities like +6, +11, −18, +19, del(1) (q11-q25), del(4p15), del(7)(q22-23), del(13)(q14q22), del(18p11), t(10q24), t(11q21-q23), t(12p13), t(14q32), t(14p11) although not recurrent but have been described previously in B-CLL [7] - [9] [23] [25] . A large scale karyotyping data is required to check the recurrence of the abnormal chromosomal loci in our study.
The complex karyotype displayed FISH targeted recurrent aberrations like del(13q14), +12, del(17p13), del(11q22), del(6q22) as well as non-targeted numerical and structural abnormalities, which were also detected in non-complex abnormal karyotypes. The significant correlation of complex karyotype with del(11q22) and/or del(17p) and also with FISH subgroup, coexistence of ≥2 abnormalities supports and reflects the fact that B-CLL with complex genome may be a consequence of progressive genomic instability with poor prognosis. This is supported by recent findings that showed complex karyotype with association of poor prognostic markers like del(17p), unmutated IgVH, decreased event free survival, chemo refractory to standard Fludarabine and also targeted Ibrutinib-based regimens [9] [32] [35] [38] . Recently, Thompson et al. [32] reported that complex karyotype is an independent powerful predictor of outcome of targeted Ibrutinib-based regimen as well as stronger predictor of biological behavior than del(17p).
Recently, Sanger sequencing and next generation sequencing have identified new genomic abnormalities such as NOTCH1, SF3B1, and MYD88 & BIRC3 mutations along with TP53 deletion/point mutation. NOTCH1 mutation is associated with higher risk of Richter Syndrome transformation. SF3B1 mutation is associated with chemo resistance to alkylating/Fludarabine therapy. BIRC3 mutation is associated with chemorefractory, relapsed disease and found to be very high risk, independent prognostic marker [15] [16] [18] [19] [30] [39] [40] . These mutation markers along with integrated cytogenetic findings will contribute in better refinement of prognostic groups in B-CLL.
5. Conclusion
In conclusion, our study shows that interphase FISH with integration of conventional karyotyping is powerful strategy, able to identify not only recurrent targeted abnormalities but also genomic complexity with clinical significance that helped identification of additional prognostic subclasses. The point mutation markers along with integrated cytogenetic findings will contribute in better refinement of prognostic groups and help design risk-adapted treatment strategies in B-CLL.
Cite this paper
P. S. Kadam Amare,S. Kakade,K. Chopra,M. Sengar,H. Menon,H. Jain,B. Bagal,P. G. Subramanian,S. Gujral, (2016) Comprehensive Genetic Analysis by Integration of Conventional Karyotyping and Interphase FISH Helps Refinement of Biological Subclasses with Clinical Impact in Chronic Lymphocytic Leukemia. Journal of Cancer Therapy,07,427-438. doi: 10.4236/jct.2016.76045
References
- 1. Hallek, M., Cheson, B.D., Catovsky, D., Caligaris-Cappio, F., et al. (2002) Guidelines for the Diagnosis and Treatment of Chronic Lymphocytic Leukemia: A Report from the International Workshop on Chronic Lymphocytic Leukemia Updating the National Cancer Institute-Working Group 1996 Guidelines. Blood, 111, 5446-5456.
http://dx.doi.org/10.1182/blood-2007-06-093906 - 2. Müller-Hermelink, H.K., Montserrat, E., Catovsky, D., Campo, E., et al. (2008) Chronic Lymphocytic Leukemia/Small Lymphocytic Lymphoma. In: Swerdlow, S.H., Campo, E., Harris, N.L., Jaffe, E.S., Pileri, S.A., Stein, H., Thiele, J. and Vardiman, J.W., Eds., World Health Organization Classification of Tumours, Pathology and Genetics of Tumours of Haematopoietic and Lymphoid Tissues, IARC, Lyon, 180-182.
- 3. Bulian, P., Tarnani, M., Rossi, D., Forconi, F., et al. (2011) Multicentre Validation of a Prognostic Index for Overall Survival in Chronic Lymphocytic Leukaemia. Hematological Oncology, 29, 91-99.
http://dx.doi.org/10.1002/hon.959 - 4. Wierda, W.G., O’Brien, S., Wang, X., Faderl, S., et al. (2011) Multivariable Model for Time to First Treatment in Patients with Chronic Lymphocytic Leukemia. Journal of Clinical Oncology, 29, 4088-4095.
http://dx.doi.org/10.1200/JCO.2010.33.9002 - 5. Rai, K.R., Sawitsky, A., Cronkite, E.P., Chanana, A.D., et al. (1975) Levy RN, Pasternack BS. Clinical Staging of Chronic Lymphocytic Leukemia. Blood, 46, 219-234.
- 6. Binet, J.L., Auquier, A., Dighiero, G., Chastang, C., et al. (1981) A New Prognostic Classification of Chronic Lymphocytic Leukemia Derived from a Multivariate Survival Analysis. Cancer, 48, 198-206.
http://dx.doi.org/10.1002/1097-0142(19810701)48:1<198::AID-CNCR2820480131>3.0.CO;2-V - 7. Dicker, F., Schnittger, S., Haferlach, T., Kern, W., et al. (2006) Immunostimulatory Oligonucleotide-Induced Metaphase Cytogenetics Detect Chromosomal Aberrations in 80% of CLL Patients: A Study of 132 CLL Cases with Correlation to FISH, IgVH Status, and CD38 Expression. Blood, 108, 3152-3160.
http://dx.doi.org/10.1182/blood-2006-02-005322 - 8. Mayr, C., Speicher, M., Kofler, D., Buhmann, R., et al. (2006) Translocations Are Associated with Poor Prognosis in Chronic Lymphocytic Leukemia. Blood, 107, 742-751.
http://dx.doi.org/10.1182/blood-2005-05-2093 - 9. Haferlach, C., Dicker, F., Schnittger, S., Kern, F., et al. (2007) Comprehensive Genetic Characterization of CLL: A Study on 506 Cases Analysed with Chromosome Banding Analysis, Interphase FISH, IgVH Status and Immunophenotyping. Leukemia, 21, 2442-2451.
http://dx.doi.org/10.1182/blood-2005-05-2093 - 10. Xu, W., Li, J.Y., Pan, J.L., Qui, H.R., et al. (2007) Interphase Fluorescence in Situ Hybridization Detection of Cytogenetic Abnormalities in B-Cell Chronic Lymphocytic Leukemia. International Journal of Hematology, 85, 430e6.
- 11. Quijano, S., Lopez, A., Rasillo, A., Sayague’s, J.M., et al. (2008) Impact of Trisomy 12, del(13q), del(17p), and del(11q) on the Immunophenotype, DNA Ploidy Status, and Proliferative Rate of Leukemic B-Cells in Chronic Lymphocytic Leukemia. Cytometry Part B: Clinical Cytometry, 74, 139e49.
http://dx.doi.org/10.1002/cyto.b.20390 - 12. Durak, B., Akay, O., Aslan, V., Ozdemir, M., et al. (2009) Prognostic Impact of Chromosome Alterations Detected by FISH in Turkish Patients with B-Cell Chronic Lymphocytic Leukemia. Cancer Genetics and Cytogenetics, 188, 65e69.
http://dx.doi.org/10.1016/j.cancergencyto.2008.08.019 - 13. Kotkowska, A., Wawrzyniak, E., Blonski, J.Z., Robak, T., et al. (2011) Chromosomal Aberrations in Chronic Lymphocytic Leukemia Detected by Conventional Cytogenetics with DSP30 as a Single Agent: Comparison with FISH. Leukemia Research, 35, 1032-1038.
http://dx.doi.org/10.1016/j.leukres.2011.01.020 - 14. Jaglowski, S.M., Ruppert, A.S., Heerema, N.A., Bingman, A., et al. (2012) Complex Karyotype Predicts for Inferior Outcomes Following Reduced Intensity Conditioning Allogeneic Transplant for Chronic Lymphocytic Leukaemia. The British Journal of Haematology, 159, 82-87.
http://dx.doi.org/10.1111/j.1365-2141.2012.09239.x - 15. Quesada, V., Conde, L., Villamor, N., Ordónez, G., et al. (2012) Exome Sequencing Identifies Recurrent Mutations of the splicing Factor SF3B1 Gene in Chronic Lymphocytic Leukemia. Nature Genetics, 44, 47-52.
http://dx.doi.org/10.1038/ng.1032 - 16. Rossi, D., Rasi, S., Spina, V., Fangazio, M., et al. (2012) Different Impact of NOTCH1 and SF3B1 Mutations on the Risk of Chronic Lymphocytic Leukemia Transformation to Richter Syndrome. British Journal of Haematology, 158, 426-429.
http://dx.doi.org/10.1111/j.1365-2141.2012.09155.x - 17. Kadam Amare, P.S., Gadage, V., Jain, H., Nikalje, S., Sengar, M., Mittal, N., Gujral, S. and Nair, R. (2013) Clinico-Pathological Impact of Cytogenetic Subgroups in B-Cell Chronic Lymphocytic Leukemia: Experience from India. Indian Journal of Cancer, 50, 261-267.
http://dx.doi.org/10.4103/0019-509X.118730 - 18. Rossi, D., Rasi, S., Spina, V., Bruscaggin, A., et al. (2013) Integrated Mutational and Cytogenetic Analysis Identifies New Prognostic Subgroups in Chronic Lymphocytic Leukemia. Blood, 121, 1403-1412.
http://dx.doi.org/10.1182/blood-2012-09-458265 - 19. Jeromin, S., Weissmann, S., Haferlach, C., Dicker, F., et al. (2014) SF3B1 Mutations Correlated to Cytogenetics and Mutations in NOTCH1, FBXW7, MYD88, XPO1 and TP53 in 1160 Untreated CLL Patients. Leukemia, 28, 108-117.
http://dx.doi.org/10.1038/leu.2013.263 - 20. Dohner, H., Stilgenbauer, S., Benner, A., Leupolt, E., et al. (2000) Genomic Aberrations and Survival in Chronic Lymphocytic Leukemia. The New England Journal of Medicine, 343, 1910-1916.
http://dx.doi.org/10.1056/NEJM200012283432602 - 21. Ripollés, L., Ortega, M., Ortuno, F., González, A., et al. (2006) Genetic Abnormalities and Clinical Outcome in Chronic Lymphocytic Leukemia. Cancer Genetics and Cytogenetics, 171, 57-64.
- 22. Wren, C., Moriarty, H., Marsden, K. and Tegg, E. (2010) Cytogenetic Investigations of Chronic Lymphocytic Leukemia. Cancer Genetics and Cytogenetics, 198, 155-161.
http://dx.doi.org/10.1016/j.cancergencyto.2009.12.014 - 23. Travella, A., Ripollés, L., Aventin, A., et al. (2013) Structural Alterations in Chronic Lymphocytic Leukemia. Cytogenetic and FISH Analysis. Hematological Oncology, 31, 339-347.
http://dx.doi.org/10.1002/hon.2025 - 24. Shi, M., Cipollini, M., Crowley-Bish, P., Higgins, A., et al. (2013) Improved Detection Rate of Cytogenetic Abnormalities in Chronic Lymphocytic Leukemia and Other Mature B-Cell Neoplasms With Use of CpG-Oligonucleotide DSP30 and Interleukin 2 Stimulation. American Journal of Clinical Pathology, 139, 662-669.
http://dx.doi.org/10.1309/AJCP7G4VMYZJQVFI - 25. Put, N., Konings, P., Rack, K., Jamar, M., et al. (2009) Improved Detection of Chromosomal Abnormalities in Chronic Lymphocytic Leukemia by Conventional Cytogenetics Using CpG Oligonucleotide and Interleukin-2 Stimulation: A Belgian Multicentric Study. Genes, Chromosomes & Cancer, 48, 843-853.
http://dx.doi.org/10.1002/gcc.20691 - 26. Rigolin, G., Cibien, F., Martinelli, S., Formigaro, L., et al. (2012) Chromosome Aberrations Detected by Conventional Karyotyping Using Novel Mitogens in Chronic Lymphocytic Leukemia with “Normal” FISH: Correlations with Clinicobiologic Parameters. Blood, 119, 2310-2313.
http://dx.doi.org/10.1182/blood-2011-11-395269 - 27. Martín-Subero, J., Ibbotson, R., Klapper, W., Michaux, L., et al. (2007) A Comprehensive Genetic and Histopathologic Analysis Identifies Two Subgroups of B-Cell Malignancies Carrying a t(14;19)(q32;q13) or Variant BCL3-Translocation. Leukemia, 21, 1532-1544.
http://dx.doi.org/10.1038/sj.leu.2404695 - 28. Huh, Y., Schweighofer, C., Ketterling, R., Knudson, R., et al. (2011) Chronic Lymphocytic Leukemia with t(14;19) (q32;q13) Is Characterized by Atypical Morphologic and Immunophenotypic Features and Distinctive Genetic Features. American Journal of Clinical Pathology, 135, 686-696.
http://dx.doi.org/10.1309/AJCPOEFP3SLX6HXJ - 29. Cavazzini, F., Rizzotto, L., Sofritti, O., Daghia, G., et al. (2012) Clonal Evolution Including 14q32/IGH Translocations in Chronic Lymphocytic Leukemia: Analysis of Clinicobiologic Correlations in 105 Patients. Leukemia & Lymphoma, 53, 83-88.
http://dx.doi.org/10.3109/10428194.2011.606384 - 30. Rodriguez-Vicente, A.E., Diaz, M.G. and Hernandez-Rivas, J.M. (2013) Chronic Lymphocytic Leukemia: A Clinical and Molecular Heterogenous Disease. Cancer Genetics, 206, 49-62.
http://dx.doi.org/10.1016/j.cancergen.2013.01.003 - 31. Dewald, G., Brockman, S., Paternoster, S., Bone, N., et al. (2003) Chromosome Anomalies Detected by Interphase Fluorescence in Situ Hybridization: Correlation with Significant Biological Features of B-Cell Chronic Lymphocytic Leukemia. British Journal of Haematology, 121, 287-295.
http://dx.doi.org/10.1046/j.1365-2141.2003.04265.x - 32. Thompson, P., O’Brien, S., Wierda, W., Ferrajoli, A., et al. (2015) Complex Karyotype Is a Stronger Predictor than Del(17p) for an Inferior Outcome in Relapsed or Refractory Chronic Lymphocytic Leukemia Patients Treated with Ibrutinib-Based Regimens. Cancer, 121, 3612-3621.
http://dx.doi.org/10.1002/cncr.29566 - 33. Orlandi, E., Bernasconi, P. and Pascutto, C. (2012) The Prognostic Difference of Monoallelic versus Biallelic Deletion of 13q in Chronic Lymphocytic Leukemia. Cancer, 118, 5179.
http://dx.doi.org/10.1002/cncr.27525 - 34. O’Brien, S. (2012) Reply to the Prognostic Difference of Monoallelic versus Biallelic Deletion of 13q in Chronic Lymphocytic Leukemia. Cancer, 118, 5180.
http://dx.doi.org/10.1002/cncr.27524 - 35. Oliveira, A., de la Banda, E., Domingo-Domenech, E., Encuentra, M., et al. (2011) Prospective Study of Clinical and Biological Prognostic Factors at Diagnosis in Patients with Early Stage B-Cell Chronic Lymphocytic Leukemia. Leukemia & Lymphoma, 52, 429-435.
http://dx.doi.org/10.3109/10428194.2010.545463 - 36. Parker, H., Rose-Zerilli, M., Parker, A., Chaplin, T., et al. (2011) 13q Deletion Anatomy and Disease Progression in Patients with Chronic Lymphocytic Leukemia. Leukemia, 25, 489-497.
http://dx.doi.org/10.1038/leu.2010.288 - 37. Palamarchuk, A., Efanov, A., Nazaryan, N., Santanam, U., et al. (2010) 13q14 Deletions in CLL Involve Cooperating Tumor Suppressors. Blood, 115, 3916-3922.
http://dx.doi.org/10.1182/blood-2009-10-249367 - 38. Farooqui, M.Z.H., Valdez, J., Martyr, S., Aue, G., et al. (2015) Ibrutinib for Previously Untreated and Relapsed or Refractory Chronic Lymphocytic Leukemia with TP53 Aberrations: A Phase 2, Single-Arm Trial. The Lancet Oncology, 16, 169-176.
http://dx.doi.org/10.1016/S1470-2045(14)71182-9 - 39. Foà, R., Del, Giudice, I., Guarini, A., Rossi, D. and Gaidano, G. (2013) Clinical Implications of the Molecular Genetics of Chronic Lymphocytic Leukemia. Hematologica, 98, 675-685.
http://dx.doi.org/10.3324/haematol.2012.069369 - 40. Puiggros, A., Blanco, G. and Espinet, B. (2014) Genetic Abnormalities in Chronic Lymphocytic Leukemia: Where We Are and Where We Go. BioMed Research International, 2014, Article ID: 435983.
http://dx.doi.org/10.1155/2014/435983
NOTES

*Corresponding author.






